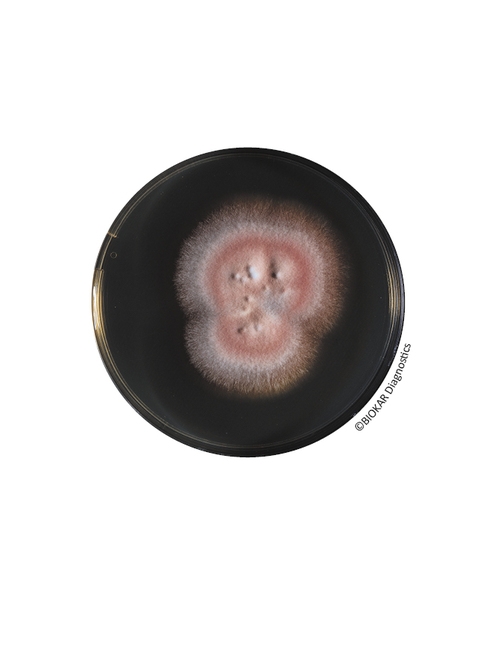
img

Sabouraud Dextrose Agar (SDA)
Sabouraud Dextrose Agar (SDA)
Sabouraud Dextrose Agar, farmasötik ve kozmetik ürünlerin sterilite testlerinde maya ve küflerin kültürü, izolasyonu ve tanımlanması için klasik bir ortamdır. Ayrıca, farmasötik ürünlerdeki Candida albicans'ın spesifik tespitinde kullanılır.

Ürün Adı: Sabouraud Dextrose Agar (SDA)
Ürün Kodu: BK025HA
Miktar: 500 g

Ürün Adı: Sabouraud Dextrose Agar (SDA)
Ürün Kodu: BM05308
Miktar: 10 şişe x 200 mL
Ürün Adı: Sabouraud Dextrose Agar (SDA)
Ürün Kodu: BM17308
Miktar: 20 Petri plates Ø 90 mm
